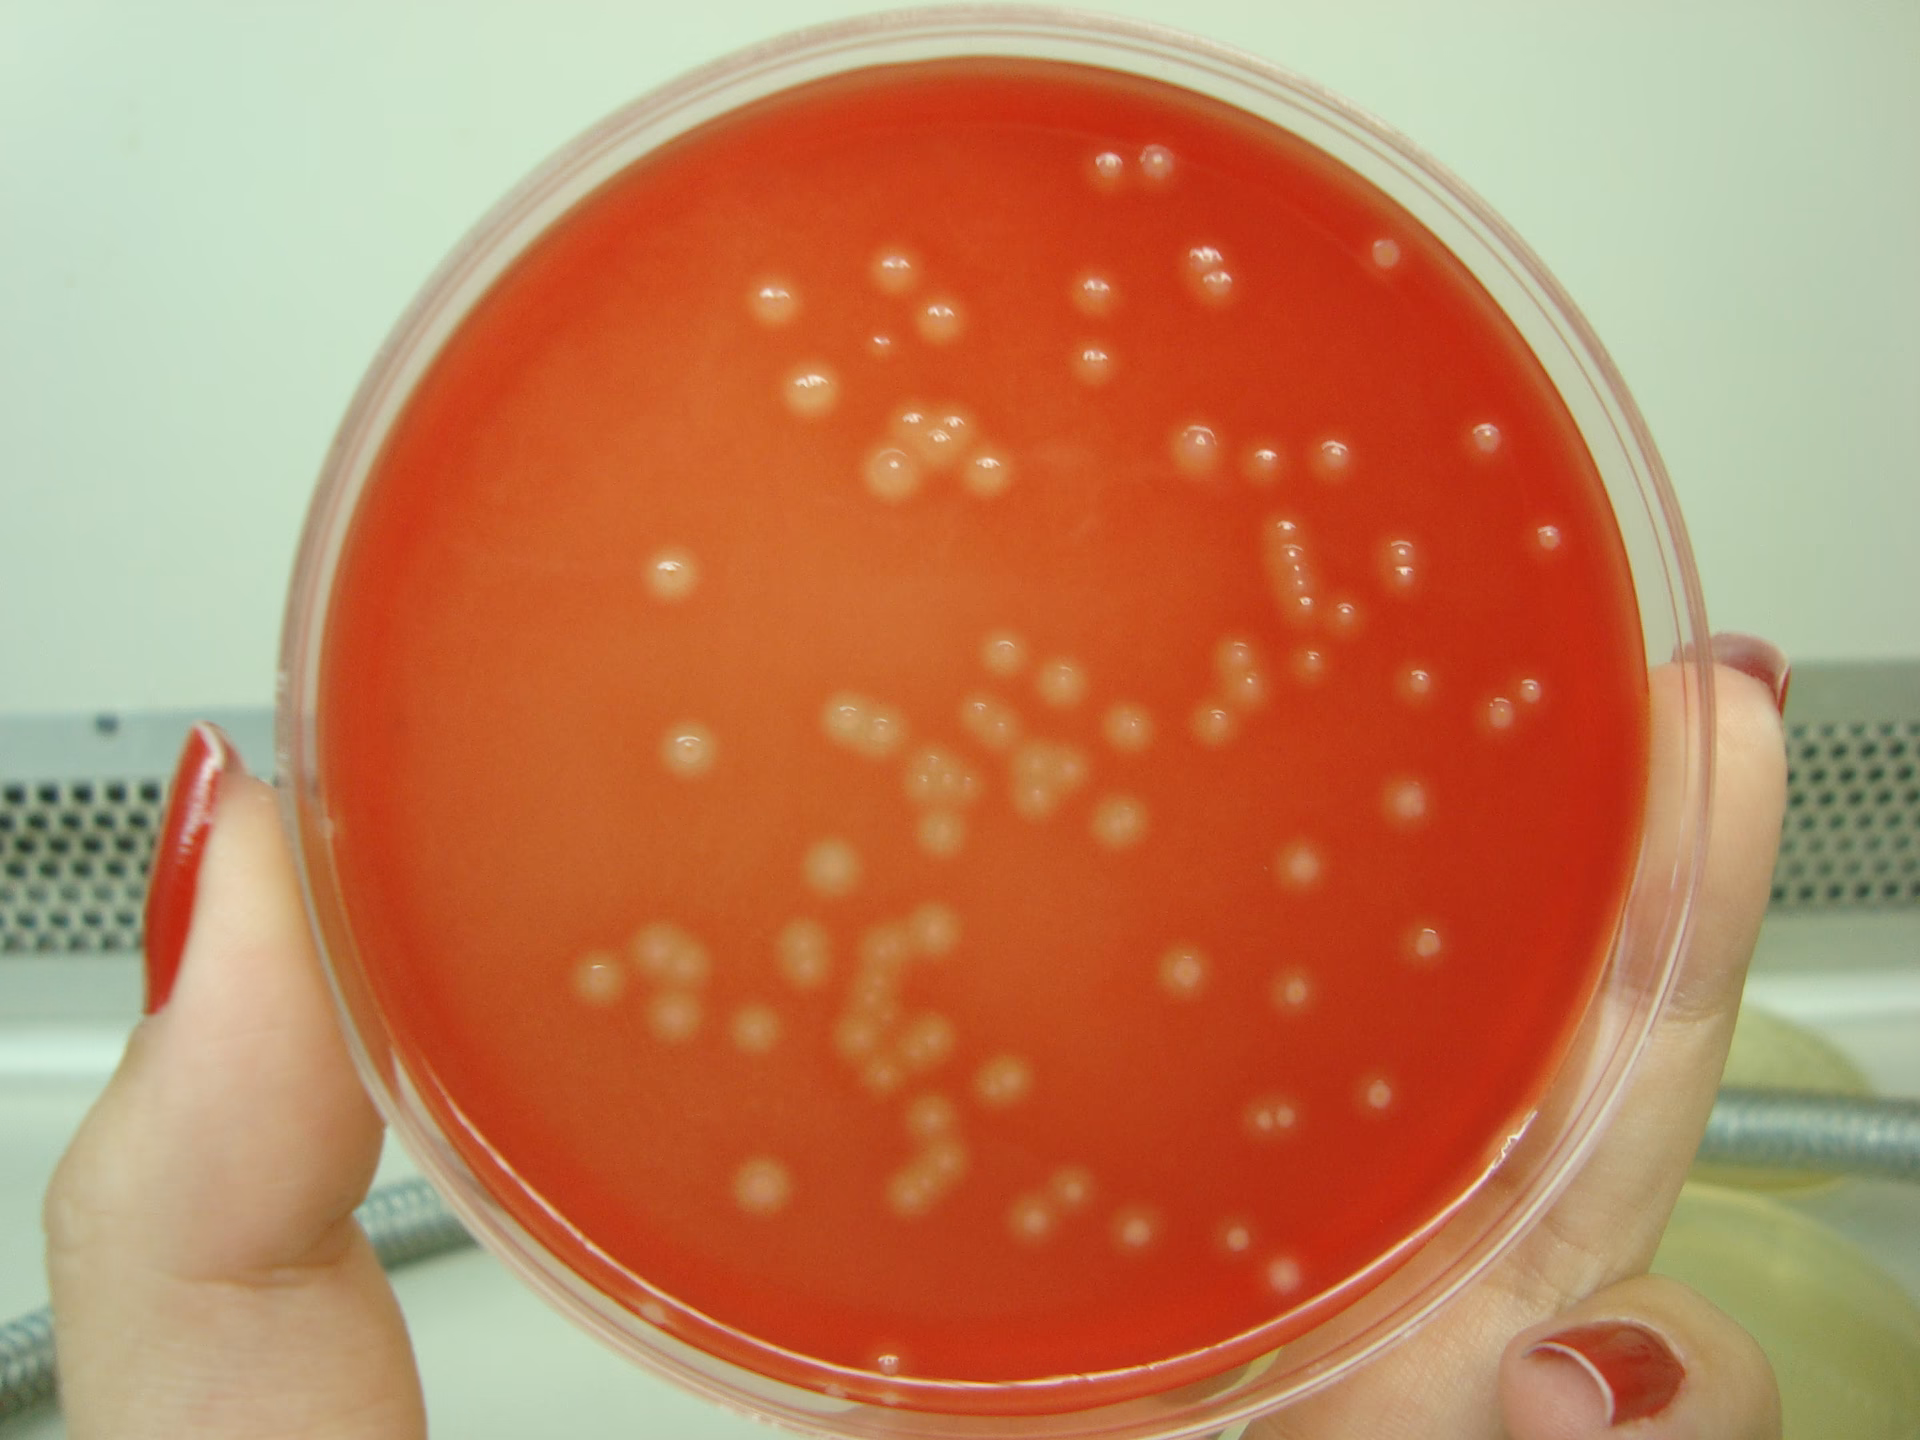
Quais são os representantes esféricos do gênero Streptococcus?

27/12/2015
Streptokokker er en slægt af kugleformede bakterier, som de fleste af os stifter bekendtskab med på et eller andet tidspunkt i livet, ofte i form af en ubehagelig halsbetændelse. Men denne store familie af mikroorganismer er langt mere kompleks end som så. Mens mange arter lever i harmoni med os som en del af vores normale bakterieflora i munden, på huden, i tarmen og luftvejene, er andre i stand til at forårsage alvorlige og endda livstruende sygdomme. At forstå forskellen på disse bakterier, hvordan de klassificeres, og hvilke sygdomme de forårsager, er afgørende for både forebyggelse og effektiv behandling. Denne artikel vil guide dig igennem alt, hvad der er værd at vide om Streptokokker.

Hvad er Streptokokker? En grundlæggende introduktion
Slægten Streptococcus tilhører familien Streptococcaceae. Navnet stammer fra græsk, hvor "streptos" betyder snoet eller kæde, og "kokkos" betyder bær, hvilket præcist beskriver deres udseende under et mikroskop: kugleformede bakterier (kokker), der arrangerer sig i kæder. De er grampositive, hvilket er en mikrobiologisk klassifikation baseret på bakteriens cellevægsstruktur og dens evne til at fastholde en bestemt farve (krystalviolet) under en farvningsprocedure.
De fleste streptokok-arter foretrækker iltholdige miljøer (er aerobe), men de er fakultativt anaerobe, hvilket betyder, at de også kan vokse og trives i iltfattige omgivelser. En interessant biokemisk egenskab er, at de er homofermentative. Det betyder, at når de fermenterer sukkerarter for at skaffe energi, er det primære og næsten eneste slutprodukt mælkesyre. Denne egenskab er særligt relevant for den art, der forårsager huller i tænderne.
Overførsel og overlevelse
Da streptokokker er en naturlig del af menneskets flora, er smittevejene mange og ofte uundgåelige. De spredes let ved direkte kontakt, for eksempel via spyt ved kys, deling af bestik eller glas, eller via dråbesmitte, når en smittet person hoster eller nyser. Selvom de er sårbare over for almindelige rengøringsmidler og desinfektion, er de bemærkelsesværdigt modstandsdygtige over for udtørring, hvilket gør det muligt for dem at overleve på overflader i en periode.
Klassificering af Streptokokker: Forståelse af forskellene
For at kunne skelne mellem de mange forskellige streptokok-arter og deres potentiale for at forårsage sygdom, anvender mikrobiologer og læger primært to klassificeringssystemer.
1. Klassificering baseret på Hæmolyse
Denne metode ser på bakteriens evne til at nedbryde røde blodlegemer (hæmolyse), når den dyrkes på en agarplade, der indeholder blod. Mønsteret af hæmolyse er en vigtig indikator for bakteriens potentielle sygdomsfremkaldende egenskaber.
- Alfa-hæmolytiske (α-hæmolyse): Disse bakterier forårsager en ufuldstændig eller delvis nedbrydning af de røde blodlegemer. Dette skaber en grønlig zone omkring bakteriekolonierne på agarpladen. Eksempler inkluderer Streptococcus pneumoniae og arter fra Viridans-gruppen.
- Beta-hæmolytiske (β-hæmolyse): Disse er de mest aggressive. De forårsager en fuldstændig nedbrydning af de røde blodlegemer, hvilket resulterer i en klar, gennemsigtig zone omkring kolonierne. De mest berygtede sygdomsfremkaldende streptokokker, som Streptococcus pyogenes (Gruppe A), tilhører denne kategori.
- Gamma-hæmolytiske (γ-hæmolyse): Disse bakterier udviser ingen hæmolyse. De nedbryder ikke de røde blodlegemer, og der ses ingen forandring i agaren omkring dem. De er generelt mindre sygdomsfremkaldende.
2. Lancefield-Klassificering
Dette system, udviklet af Rebecca Lancefield, grupperer streptokokker baseret på specifikke kulhydrater (antigener) i bakteriens cellevæg. Det er primært de beta-hæmolytiske streptokokker, der klassificeres på denne måde i grupper benævnt med bogstaver (A, B, C, D, etc.).
Vigtige Streptokok-arter og de Sygdomme, de Forårsager
Lad os dykke ned i de klinisk mest relevante grupper og arter, som læger og patienter oftest støder på.
Gruppe A Streptokokker (GAS) - Streptococcus pyogenes
Dette er uden tvivl den mest kendte og klinisk betydningsfulde gruppe. S. pyogenes er beta-hæmolytisk og står bag en lang række infektioner, fra milde til livstruende.
- Halsbetændelse (Faryngitis): Den mest almindelige GAS-infektion. Symptomerne inkluderer pludselig og kraftig ondt i halsen, synkesmerter, feber, hævede og røde mandler (ofte med hvide belægninger), og hævede lymfeknuder på halsen. Det er vigtigt at skelne den fra viral halsbetændelse, da bakteriel halsbetændelse kræver behandling med antibiotika for at forhindre komplikationer.
- Hudinfektioner: GAS kan forårsage impetigo (børnesår), en overfladisk hudinfektion med blærer og gullige skorper, samt erysipelas (rosen), en dybere infektion i huden, der giver et skarpt afgrænset, rødt og hævet udslæt.
- Skarlagensfeber: Dette er en komplikation til halsbetændelse, hvor bakterien producerer et toksin, der forårsager et karakteristisk sandpapir-lignende udslæt over hele kroppen og en "jordbærtunge".
- Alvorlige komplikationer: Hvis en GAS-infektion ikke behandles, kan den føre til alvorlige følgesygdomme. Disse inkluderer gigtfeber, en inflammatorisk tilstand, der kan give permanent skade på hjerteklapperne, og akut glomerulonefritis, en betændelsestilstand i nyrerne.
Gruppe B Streptokokker (GBS) - Streptococcus agalactiae
Denne art er især bekymrende i forbindelse med graviditet og fødsel. GBS er en del af den normale bakterieflora i tarmen og skeden hos op mod 35% af alle raske kvinder. For kvinden selv er bakterien typisk harmløs, men den kan overføres til barnet under fødslen og forårsage alvorlig sygdom hos den nyfødte.
- Sygdom hos nyfødte: GBS er en af de hyppigste årsager til blodforgiftning (sepsis) og hjernehindebetændelse (meningitis) hos spædbørn. Dette er livstruende tilstande, der kræver øjeblikkelig hospitalsindlæggelse og behandling. Derfor screenes gravide kvinder ofte for GBS, og der gives forebyggende antibiotika under fødslen, hvis bakterien påvises.
Pneumokokker - Streptococcus pneumoniae
Disse alfa-hæmolytiske bakterier er en af de mest alvorlige patogener for mennesker og en hyppig årsag til sygdom og død verden over, især blandt små børn og ældre. De er kendt for at have en kapsel, der beskytter dem mod kroppens immunsystem.
- Lungebetændelse (Pneumoni): Som navnet antyder, er pneumokokker den mest almindelige bakterielle årsag til lungebetændelse.
- Meningitis (Hjernehindebetændelse): En meget alvorlig infektion i hinderne omkring hjernen og rygmarven.
- Bakteriæmi og Sepsis: Bakterier i blodbanen, som kan føre til en livstruende tilstand med organsvigt.
- Mellemørebetændelse (Otitis Media) og Bihulebetændelse (Sinusitis): Meget almindelige, mindre alvorlige infektioner, især hos børn.
Heldigvis findes der effektive vacciner mod de mest almindelige typer af pneumokokker, som er en del af børnevaccinationsprogrammet i mange lande.
Viridans-gruppen og Streptococcus mutans
Disse er primært alfa-hæmolytiske streptokokker, der udgør en stor del af den normale mundflora.
- Caries (Huller i tænderne):Streptococcus mutans spiller en hovedrolle i udviklingen af caries. Bakterien klæber sig til tændernes overflade og omdanner sukker fra kosten til mælkesyre. Denne syre nedbryder langsomt tandemaljen, hvilket fører til huller.
- Endokarditis: Selvom de normalt er harmløse i munden, kan Viridans-streptokokker blive farlige, hvis de kommer over i blodbanen, f.eks. i forbindelse med et tandlægebesøg eller dårlig mundhygiejne. Hos personer med eksisterende hjerteklapsygdomme kan bakterierne sætte sig på hjerteklapperne og forårsage endokarditis, en alvorlig infektion i hjertets indre hinde.
Sammenligningstabel over Almindelige Streptokok-infektioner
| Infektion | Typisk Bakterie | Almindelige Symptomer | Behandling |
|---|---|---|---|
| Halsbetændelse | S. pyogenes (Gruppe A) | Ondt i halsen, feber, hævede mandler med belægning | Penicillin eller andet antibiotika |
| Lungebetændelse | S. pneumoniae (Pneumokok) | Hoste, feber, åndenød, brystsmerter | Antibiotika, evt. hospitalsindlæggelse |
| Caries (huller) | S. mutans | Tandpine, isninger, synlige huller | Tandlægebehandling, forebyggelse |
| Nyfødt-sepsis | S. agalactiae (Gruppe B) | Sløvhed, feber, vejrtrækningsproblemer | Akut behandling med intravenøs antibiotika |
| Rosen (Erysipelas) | S. pyogenes (Gruppe A) | Skarpt afgrænset, rødt, varmt og hævet hudområde | Antibiotika |
Ofte Stillede Spørgsmål (FAQ)
Er alle streptokokker farlige?
Nej, absolut ikke. Langt de fleste streptokok-arter er harmløse og en vigtig del af vores normale bakterieflora, især i munden og svælget. Det er kun et fåtal af arterne, som S. pyogenes og S. pneumoniae, der er kendt for at forårsage alvorlig sygdom.
Hvad er forskellen på en virus-halsbetændelse og en streptokok-halsbetændelse?
Selvom symptomerne kan ligne hinanden, er der nogle forskelle. Streptokok-halsbetændelse starter ofte meget pludseligt med høj feber og udtalt ondt i halsen, men typisk uden hoste og snue, som ofte ledsager en viral infektion. Hvide belægninger på mandlerne er også mere typisk for bakterier. Den eneste sikre måde at kende forskel på er ved en podning fra halsen (en Strep A-test).
Kan man blive immun over for streptokokker?
Man kan udvikle immunitet mod den specifikke type af f.eks. S. pyogenes, man har været smittet med. Problemet er, at der findes mange forskellige undertyper (serotyper) af bakterien, så man kan desværre godt få streptokok-halsbetændelse flere gange i sit liv.
Hvorfor er det så vigtigt at færdiggøre en antibiotikakur?
Det er afgørende at tage hele den ordinerede antibiotikakur, selvom man føler sig rask efter et par dage. Stopper man for tidligt, risikerer man, at de mest resistente bakterier overlever og formerer sig. Dette kan føre til, at infektionen vender tilbage, og det bidrager til det globale problem med antibiotikaresistens. For Gruppe A streptokokker specifikt, sikrer en fuld behandling også, at man minimerer risikoen for alvorlige følgesygdomme som gigtfeber.
Konklusion
Streptokokker er en mangfoldig og fascinerende gruppe af bakterier, der spænder fra at være harmløse medpassagerer i vores krop til at være årsag til alvorlige infektioner. Viden om de forskellige typer, deres smitteveje og de sygdomme, de kan medføre, er essentiel. God hygiejne, rettidig diagnose hos lægen, korrekt brug af antibiotika og vaccination er vores stærkeste våben i kampen mod de sygdomsfremkaldende streptokokker og for at opretholde et sundt liv.
Hvis du vil læse andre artikler, der ligner Streptokokker: Den Komplette Guide til Bakterien, kan du besøge kategorien Sundhed.